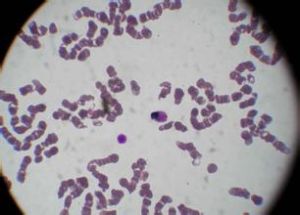
低增生性急性白血病

低增生性急性白血病低增生性急性白血病(hypoproliferative acute leukemia,HAL)是急性白血病(AL)中的一種少見類型。絕大多數急性白血病患者骨髓增生程度在活躍以上,約10%左右的急性白血病發病時為全血細胞減少,外周血可無幼稚細胞,無肝脾淋巴結腫大骨髓活檢增生減低,幼稚細胞比例占5%~75%。這類患者常被稱為“冒煙性白血病”或白血病前期。但由於其臨床特點與增生活躍的急性白血病相似多數學者認為稱之為低增生性白血病(hypoproliferative leukemia)更為合適。其特點為骨髓增生低下,但原始細胞仍>30%。HAL對化療耐受性差,緩解率低,預後不佳。HAL絕大多數見於急性髓細胞白血病(AML),占AML的5%~10%,患者年齡通常大於50歲部分HAL由骨髓增生異常綜合徵(MDS)轉化而來,或以往曾接受化療或放療,即屬繼發性白血病。由於HAL化療效果差,故有作者主張及早進行異體造血幹細胞移植,已有成功的報導但HAL發病時,多數患者已超過50歲,適合於移植者很少。
流行病學
約75%的患者年齡在50歲以上,男∶女=3∶1,占AML的5%~10%。
病因
病因人類白血病的確切病因至今未明,許多因素被認為和白血病發生有關。病毒可能是主要因素此外尚有遺傳放射、化學毒物或藥物等因素。
1.病毒 已證實雞、小鼠貓、牛和長臂猿等動物的自發性白血病組織中可分離出白血病病毒,為一種反轉錄病毒,在電鏡下大多呈C型形態。反轉錄病毒是RNA病毒,進入細胞漿去掉被膜後釋放出RNA。在反轉錄酶的作用下,以病毒RNA為模板轉錄為互補DNA(即前體病毒DNA),再經過DNA依賴性DNA多聚酶的作用形成前病毒DNA。前病毒DNA能整合到宿主細胞的DNA內進行複製但不影響宿主細胞的生存。人類白血病的病毒病因研究已有數十年的歷史但至今只有成人T細胞白血病肯定是由病毒引起的。1976年日本高月清首先報導成人T細胞白血病/淋巴瘤(ATL),以後的流行病學調查發現日本西南部、加勒比海區域及中部非洲為高發流行區。1980年在ATL細胞系中發現ATL相關抗原並在電鏡下發現了病毒顆粒美國Gallo和日本的日昭賴夫分別從病人培養細胞株中分離出C型反轉錄RNA病毒,分別命名為HTLV-1和ATLV,以後證實二者是一致的。這是對人類白血病病毒病因研究的重大貢獻。ATL高發區也是HTLV-1感染的高發區日本血清流行病學調查表明流行區40歲以上健康人群中HTLV-1抗體陽性率達6%~37%,而非流行區抗體陽性率僅0~0.015%HTLV-1具有傳染性,可通過乳汁母嬰傳播,通過性交和輸血傳播。中國曾毅等對28省、市、自治區進行人群血清流行病學調查,發現8例HTLV-1抗體陽性者大都系日本人或與其有密切接觸者。1989年呂聯煌在福建沿海地區發現HTLV-1小流行區。其他病毒如HTLV-2和毛細胞白血病、EB病毒和ALL-L3亞型(Burkitt白血病/淋巴瘤)的關係尚未完全肯定。其他類型的白血病尚無法證實其病毒病因,並不具有傳染性。
2.放射 電離輻射有致白血病作用,其作用與放射劑量大小和照射部位有關。一次大劑量或多次小劑量照射均有致白血病作用。全身照射特別是骨髓受到照射,可致骨髓抑制和免疫抑制照射後數月仍可觀察到染色體斷裂和畸變。1945年日本廣島和長崎遭核子彈襲擊後倖存者中,發生白血病數較未輻射地區高30和17倍放射治療強直性脊柱炎和32P治療真性紅細胞增多症白血病的發生率均較對照組為高。據中國1950~1980年調查,臨床X線工作者白血病的發病率為9.61/10萬(標化率9.67/10萬),而其他醫務人員為2.74/10萬(標化率2.77/10萬)放射可誘發AML、ALL和CML,但未見CLL,並且發病前常有一段骨髓抑制期,其潛伏期約為2~16年診斷性照射是否會致白血病尚無確切根據,但孕婦胎內照射可增加出生後嬰兒發生白血病的危險性。
3.化學物質 苯致白血病的作用比較肯定,在1~10ppm可引起染色體損害,124~200ppm有致白血病作用苯致急性白血病以AML和AEL為主,後者占相當比例,值得引起注意,並且在出現白血病的臨床表現之前常有一階段骨髓抑制期類似MDS苯致慢性白血病主要為CML,未見CLL。烷化劑、拓撲異構酶Ⅱ抑制劑和細胞毒藥物可致繼發性白血病也較肯定,稱治療相關性白血病(t-AL),尤其是前二類藥物。多數t-AL在原有淋巴系統惡性腫瘤和易產生免疫缺陷的惡性腫瘤經長期烷化劑治療後發生,發病間隔2~8年。化療引起的繼發性白血病以AML為主,且發病前常有一個全血細胞減少期。近年來國內陸續報導乙雙嗎啉致繼發性白血病近百例,該藥用於治療銀屑病,是一種極強的致染色體畸變物質服乙雙嗎啉後1~7年發生白血病(中位數4年)。乙雙嗎啉所致的白血病主要為AML,M3居多有報導吸菸和白血病的發病有關。
4.遺傳因素 某些白血病的發病與遺傳因素有關。單卵雙胎如一人患白血病另一人患白血病的機會為20%。家族性白血病占白血病例總數的7‰,偶見先天性白血病部分嬰兒白血病認為與遺傳因素相關,常伴有11q23(MLL)異常。某些遺傳性疾病常伴較高的白血病發病率,包括Down、Bloom、Klinefeher、Fan-
coni和Wiskott Aldrich綜合徵等如Down綜合徵的急性白血病發生率比一般人群高20倍。上述多數遺傳性疾患具有染色體畸變和斷裂但絕大多數白血病不是遺傳性疾病。
發病機制
發病機制白血病是一組造血幹細胞及祖細胞的惡性克隆性疾病,累及造血細胞的水平不一,如對AML而言可以是多能幹細胞,也可以是粒-單核細胞祖細胞,白血病細胞失去進一步分化成熟的能力,阻滯在較早階段。ALL主要累及淋系髓系幾乎均無惡性,阻滯發生在淋系較早階段。造血細胞發生白血病變的機制仍不清楚,某些染色體異常與白血病的發生有直接關係,染色體斷裂和易位可使癌基因的位置發生移動和被激活,染色體內基因結構的改變可直接引起細胞發生突變。白血病細胞染色體重排對細胞癌基因結構或調節發生改變,使基因產物發生質和量的改變,後者可能和白血病的發生和維持有一定關係如APL(M3)伴t(15;17),使位於17號染色體上的維A酸受體α(RARα)基因與位於15號染色體上的早幼粒細胞白血病(PML)基因發生融合,形成PML/RARα融合基因,其蛋白產物可阻斷粒細胞的分化。這是APL發病和全反式維A酸治療有效的分子機制。如CML的Ph染色體即t(9;22),形成BCR/ABL融合基因其編碼的蛋白具有較高的酪氨酸激酶活性能刺激造血細胞增殖。如ALL-L3伴t(8;14)導致8號染色體上的C-MYC基因與14號染色體上的免疫球蛋白重鏈基因並列,染色體易位使C-MYC基因的轉錄發生改變,從而破壞了與C-MYC蛋白有關的正常網路,C-MYC基因激活或過度表達引起腫瘤的發生。白血病的發生可能有一個過程,有些急性白血病是在骨髓增生異常或骨髓增殖症的基礎上發生的。白血病引起正常血細胞減少、造血衰竭的機制複雜不僅有骨髓白血病細胞的排擠,可能還有細胞和體液介導的造血抑制。
臨床表現
臨床表現患者大多為老年人,隱匿起病以頭暈乏力、心悸、氣短等貧血症狀最為多見。皮膚、黏膜出血常見,以輕、中度出血為主。少數患者以發熱、感染為臨床特徵。白血病細胞浸潤的徵象較輕,淋巴結、肝、脾一般不腫大
併發症:
1.感染、發熱是最常見的併發症,可反覆感染。
2.貧血嚴重可並發貧血性心臟病。
3.出血多見於皮膚黏膜出血
診斷
診斷1.中國診斷標準
(1)臨床上肝脾、淋巴結一般不腫大
(2)實驗室檢查:
①外周血常呈全血細胞減少,偶見原始細胞或幼稚細胞。
②2次以上不同部位骨髓檢查均呈增生減低有核細胞少,但原始細胞在30%以上。
③骨髓活體組織檢查證實。
國外Beard等在1975年曾提出HAL的診斷標準,和中國診斷標準大致相同,惟要求骨髓原始細胞>40%。如果結合FAB診斷AL的標準,原始細胞還是以>30%為妥。
2.診斷評析 隱匿起病,以貧血及輕、中度皮膚黏膜出血為主要臨床表現而白血病浸潤的體徵輕或缺如,全血細胞減少不伴白血病細胞的血象等都是HAL的特徵。診斷必須根據2個以上部位骨髓增生低下,且原始細胞>30%。診斷困難者需經骨髓活檢證實。
由於AL的部分病例,骨髓中白血病細胞極度增生,或合併骨髓纖維化,或發生骨髓壞死均可導致取材不佳,易誤認為骨髓增生低下。因此,骨髓活檢往往是診斷HAL的必經步驟。
鑑別診斷
1.再生障礙性貧血(AA) 貧血出血、全血細胞減少及骨髓增生低下是AA的主要特點,和HAL類似。兩者主要鑑別點是骨髓塗片和(或)骨髓活檢找到白血病細胞,而AA則主要為成熟的淋巴細胞。
2.骨髓增生異常綜合徵(MDS) MDS中的難治性貧血伴原始細胞增多(RAEB)及難治性貧血伴原始細胞增多轉變型(RAEB-t)患者的骨髓,可有低百分數的原始細胞,尤其是骨髓增生低下的MDS易和HAL混淆。鑑別點是:①原始細胞百分數最為主要≥30%為HAL<30%則為RAEB或RAEB-t。②病態造血。HAL常缺如,或程度很輕而MDS病態造血是診斷的必備條件
檢查
實驗室檢查:
1.血象 大多數呈全血細胞減少,且十分明顯,但很少出現白血病細胞故表現為非白血病性白血病。
2.骨髓象增生低下,原始細胞≥30%。
其它輔助檢查:
1.骨髓活檢病理 造血細胞增生低下,但仍有白血病細胞浸潤的證據。低增生性白血病的診斷需結合骨髓塗片(需多部位穿刺)和骨髓活檢確診Howe等根據骨髓活檢的造血細胞面積將低增生性白血病分為三種情況:①增生重度減低:造血細胞面積<15%;②增生中度減低:造血細胞面積在15%~30%;③增生輕度減低:造血細胞面積占30%~40%。
2.B 超 一般無肝脾腫大,淋巴結腫大。
3.X線 可提示肺部感染
治療
治療2.小劑量阿糖胞苷聯合阿地白介素(γIL-)治療阿糖胞苷(Ara-C )30~50mg/d,皮下注射,每2小時1次, 連用2~3周,休息1周,反覆使用2~5個療程;阿地白介素(γIL-2 )5~10萬U+5%葡萄糖100ml,靜滴,隔天1次,連用1~3周或反覆套用。
3.阿糖胞苷(Ara-C) 20mg/d ,皮下注射或澱粉酯鹼0.5~1mg/d靜注。
低增生性急性白血病的治療較困難Howe等認為採用強誘導緩解治療(蒽環類藥物+阿糖胞苷方案)的病例療效明顯優於單純支持治療或以潑尼松、羥基脲、巰嘌呤(6-MP)、單用阿糖胞苷為主的小劑量化療。單純支持治療組病例病情進行性發展,小劑量化療組中位生存期僅17.5個月;而強化療組完全緩解率可達70%以上中位生存期達40個月。支持治療條件較好的情況下強化療療效較好;不具備較強的支持治療條件時,開始治療強度應減弱,在化療後骨髓增生程度和白細胞計數均有改善時再行強化療更為合適。
預後
對化療耐受差緩解率低,預後不佳。